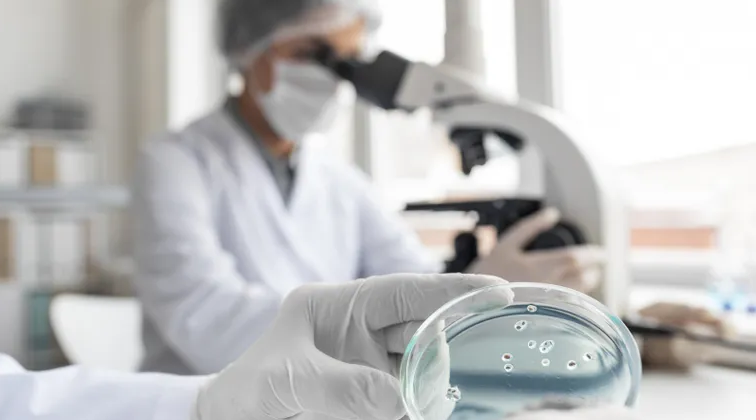

La Administración Nacional de Medicamentos, Alimentos y Tecnología Médica (Anmat) publicó la Disposición 7516/2025 en el Boletín Oficial, que marca un antes y un después para los ensayos clínicos en Argentina. Esta norma deroga las anteriores sobre estudios farmacológicos (como la Disposición 6677/10) y adapta el marco regulatorio local a estándares internacionales más exigentes.
El objetivo principal de esta actualización es fortalecer la seguridad de los participantes, garantizar la calidad y trazabilidad de los datos obtenidos y alinear el marco regulatorio nacional con los estándares internacionales más recientes. La medida apunta a consolidar un sistema de investigación clínica basado en el rigor científico, la transparencia y el respeto por los derechos de las personas involucradas.

Con la nueva normativa, Anmat reafirma su rol como autoridad competente para autorizar, supervisar y fiscalizar los estudios clínicos con fines registrales. A su vez, refuerza el requisito previo de contar con la aprobación de un Comité de Ética acreditado, con estándares claros de consentimiento informado y protección de derechos de los participantes.
Otra clave de la Disposición 7516/2025 es la integración de requisitos técnicos más modernos: desde diseño experimental hasta manejo de datos, trazabilidad, documentación y mecanismos de reporte de efectos adversos. Así, el organismo busca evitar “lagunas normativas” que puedan comprometer la calidad científica o la seguridad.
Para el ecosistema médico, farmacéutico y académico, esta actualización representa una oportunidad: Argentina podrá participar con mayor facilidad en investigaciones multicéntricas internacionales y tener datos más creíbles ante organismos reguladores de otros países. Además, se espera que la nueva normativa agilice procesos regulatorios internos al tener criterios unificados y actuales.

La Disposición 7516/2025 actualiza el marco regulatorio aplicable a los ensayos clínicos en el país, con el objetivo de reforzar los estándares de calidad científica y seguridad sanitaria. La norma busca alinear los procedimientos nacionales con las prácticas internacionales y garantizar una mayor transparencia en todas las etapas de la investigación médica.